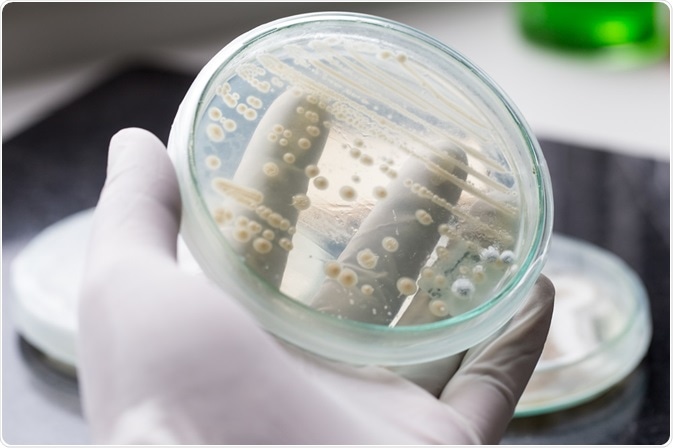

Electroporation is a technology used to increase the permeability of cell membranes. It is used to induce cells to take up a variety of substances, including chemicals, drugs, and DNA.
Credit: Rattiya Thongdumhyu/Shutterstock.com
Credit: Rattiya Thongdumhyu/Shutterstock.com
When cells take up DNA, the process is known as transformation. Bacteria, yeast, and plant protoplasts can be transformed using electroporation.
What is an electroporator?
An electroporator is a device that holds the cell suspension while voltage is applied. The cell suspension is put into a specialized container, or cuvette, with two aluminum electrodes on either side. The electrodes must come into contact with the cell suspension.
Electroporation leads to the formation of pores within the cell membrane. Electrical pulses, around 0.5-1V, are applied across the membrane, acting as a capacitor for migration of ions from solution. This induces a rearrangement of the lipid structure of the membrane, first forming a pre-pore, then a conductive pore through which DNA can pass.
Bacteria
Transformation of bacteria usually involves the use of plasmids. Plasmids are circular DNA constructs that can carry genes to be cloned and other desired functions for protein expression. A current is passed through suspended cells containing plasmid DNA in a cuvette. The cells are then allowed to grow and divide, reproducing the DNA construct.
In a typical electroporation protocol, a positive control transformation is initially carried out using uncut plasmid DNA, and a negative control with no DNA. The plasmid contains a selection factor, such as antibiotic resistance, that allows the resulting cells to be screened. The positive control sample should grow and the negative control sample should show no growth.
Compatible host cells are chosen which have the properties desired for the transformation. Electroporation is carried out with the experimental samples. If successful, the desired DNA construct can be harvested from the cells.
Yeast
Yeast cells typically have limited transformation efficiency. One protocol for optimized yeast transformation includes a combination of lithium acetate and dithiothreitol (LiAc/SS) as cell conditioning agents. These chemicals enhance yeast transformation by electroporation.
The researchers also included sorbitol and calcium chloride in the electroporation buffer. These changes resulted in increased cell volume which may have contributed to the outcome of higher transformation efficiency. Increasing quantities of DNA also resulted in increased transformation efficiency.
Another yeast transformation protocol calls for the use of LiAc/SS, as well as heat shock. A high voltage pulse is administered during electroporation to yeast cells that have been heat shocked in the presence of single-stranded carrier DNA, plasmid DNA, and polyethylene glycol (PEG). The protocol can be completed in 30 minutes.
Plant protoplasts
Sweet orange (C.sinensis) plants can be regenerated from protoplasts of the embryogenic callus of the plant. This trait has been exploited to produce numerous hybrids.
Researchers optimized electroporation efficiency of protoplasts derived from an embryogenic cell line of sweet orange, before they electroporated them in the presence of constructs designed to produce fluorescent plants.
Subsequently, they regenerated protoplast-derived calluses into plants. This works demonstrates the utility and versatility of the electroporation technique in plant protoplasts.
Further Reading
Last Updated: Jul 19, 2023